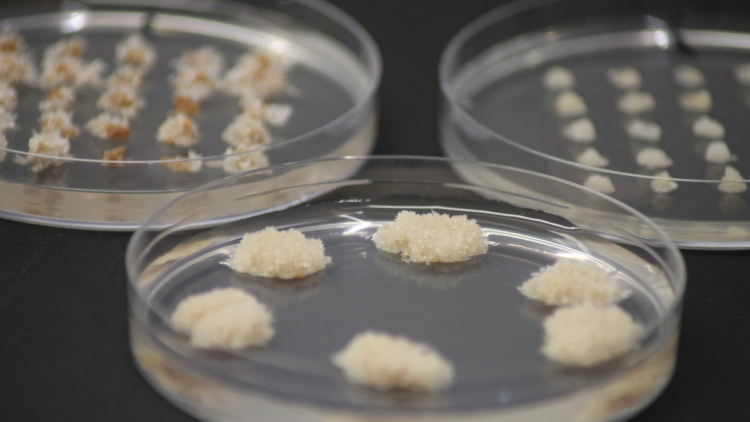

In reaching the UK’s tree planting commitments, it’s pivotal there is a sufficient supply of trees to plant, with science and Somatic Embryogenesis playing a key role.
With our changing climate at the forefront of everyone’s minds, it has become more important than ever to ensure not only a continuous and steady supply of tree stocks but also to improve tree’s quality and resilience to the effects of climate change.
Last summer’s drought proved more than ever the need to adjust our growing methods, and the government is helping to drive this with announcements of science focused funds, including the Tree Production Innovation Fund (TPIF), Tree Production Capital Grant, and the Seed Sourcing Grant, all of which will assist in enhancing the ‘quantity, quality, and diversity’ of tree planting stock in England.
Maelor Forest Nurseries’ £4 million investment into a new miniplug facility along with the work in its lab is also helping to do just this.
The Tree Production Innovation Fund
Launching in 2021, over £1 million in funding has been made available for innovative projects through the Tree Production Innovation Fund to develop new technologies and ways of working to overcome barriers to tree production and bolster domestic tree supply long into the future.
Most recently in 2022, Maelor Forest Nurseries was one of thirteen to receive funding with a proposal entitled: ‘Cryopreservation of elite cell lines to increase genetic diversity in forests’.
The project aims to form a living library of cell lines to underpin future breeding programmes. This would be done by developing a cryopreservation process for the long-term storage of cell lines and determining recovery rate and genetic fidelity of stored cell lines using next generation DNA technologies. The library would help to create the trees of the future, with a diverse portfolio of cell lines to aid future growing.
Maelor’s first project, which received funding in 2021 in partnership with Forest Research, was entitled, ‘Using Artificial Intelligence (AI) in developing image analysis software for improved productivity in advanced somatic embryogenesis systems’. It aimed to develop software to extract information from digital images of plant material, then harness the power of machine-learning to determine their quality.
This software could provide a non-invasive and real-time means for decisions at each growth production stage, which in turn, could underpin automation. For the forestry sector, automation will promote diversity of planting stock and contribute to meeting the planting targets in the UK.
So what is Somatic Embryogenesis?
Somatic embryogenesis (SE) is the process of deriving an embryo from cells. In the lab at Maelor Forest Nurseries, the process mimics the natural processes that occur in the development of seeds in the cones of a tree.
However, unlike the usual natural process, somatic embryos do not contain seed coats or megagametophytes like zygotic embryos and the process is carried out in the controlled settings of a laboratory.
Once the ‘emblings’ (the name for a plant derived from somatic embryos) have developed, they can be transplanted into soil and grown on as any seedling would.
Why do we carry out Somatic Embryogenesis?
SE is a desirable tool in forestry as it allows the large-scale propagation of genetically identical plants without the issues associated with cuttings and seeds.
Usually, trees raised from seed lack uniformity, as each seed is genetically distinct and one seed will only produce one tree. Somatic embryogenesis uses just one seed to produce thousands and potentially thousands of genetically identical emblings. All of the processes in SE are carried out in the sterile environment of the laboratory.
What are the benefits of Somatic Embryogenesis?
Genetics:
- Full-sibling families with known pedigree for both parents
- New cell lines generated each year to increase genetic diversity in planting stock
- Shorter turnaround time means that genetic gains are realised in field earlier
Performance:
- Better form as looks like a seedling
- Better juvenility so more vigorous (better health and resilience)
- Better rooting means quicker establishment in field
Production Costs
- More efficient with increasing scale of economy
- More consistent as independent of weather and other constraints
- Improved timber quality and consistency leads to increased efficiency in harvesting and sawmill
Responsive Forestry
- Wider species palette due to selection/ introduction of drought-resilient or disease-resistant species or hybrids.
- Mosaic planting means less risk due to higher genetic diversity and higher yields
- Quicker response time to changing market/environmental conditions means that new varieties or hybrids can be brought online sooner.
Looking to plant trees?
Maelor Forest Nurseries produces and supplies commercial quantities of bare root trees and shrubs suitable for forestry, hedging and native woodland planting, which can help to diversify and enhance biodiversity.
Our technical and lab work aims to improve growing conditions on the nursery to produce a better-quality plant and to ensure that this quality is maintained down the line, from dispatch to planting out and beyond.
More information about our wide range products can be found here maelor.co.uk/products or contact us here maelor.co.uk/contact-us
 https://www.maelor.co.uk/wp-content/uploads/2023/08/Norway-spruce-donning-its-spring-clothes-500x375.jpg
https://www.maelor.co.uk/wp-content/uploads/2023/08/Norway-spruce-donning-its-spring-clothes-500x375.jpg